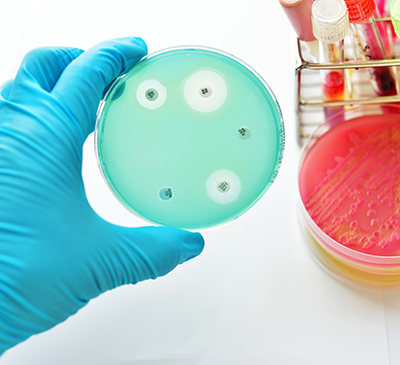
Microbial Testing Market by Application and Geography - Forecast and Analysis 2021-2025

The microbial testing market share is expected to increase by USD 2.21 billion from 2020 to 2025, and the market’s growth momentum will accelerate at a CAGR of 7.75%.
This microbial testing market research report provides valuable insights on the post COVID-19 impact on the market, which will help companies evaluate their business approaches. Furthermore, this report extensively covers microbial testing market segmentation by application (food and beverages and others, pharmaceuticals, and clinical diagnosis) and geography (North America, Europe, Asia, and ROW). The microbial testing market report also offers information on several market vendors, including 3M Co., Agilent Technologies Inc., Bio Rad Laboratories Inc., bioMerieux SA, Danaher Corp., F. Hoffmann-La Roche Ltd., Merck KGaA, PerkinElmer Inc., Shimadzu Corp., and Thermo Fisher Scientific Inc. among others.
What will the Microbial Testing Market Size be During the Forecast Period?
Download the Free Report Sample to Unlock the Microbial Testing Market Size for the Forecast Period and Other Important Statistics
Microbial Testing Market: Key Drivers, Trends, and Challenges
Based on our research output, there has been a neutral impact on the market growth during and post COVID-19 era. The high prevalence of food-borne diseases is notably driving the microbial testing market growth, although factors such as lack of skilled professionals may impede market growth. Our research analysts have studied the historical data and deduced the key market drivers and the COVID-19 pandemic impact on the microbial testing industry. The holistic analysis of the drivers will help in deducing end goals and refining marketing strategies to gain a competitive edge.
Key Microbial Testing Market Driver
The high prevalence of food-borne diseases is one of the key factors driving the growth of the global microbial testing market. Food is made of plants and animals, which usually contain many types of microorganisms. Food may be contaminated during production and consumption. For instance, raw meat may get contaminated during slaughter, and fruit and vegetables may get contaminated while growing or during processing. Hence, microbial contamination of food leads to spoilage of foods, and consumption of contaminated food results in food-borne diseases. However, the WHO collaborated with the UN Food and Agriculture Organization and created the Codex Alimentarius, a non-governmental interagency organization, which created food guidelines, standards, and practices, such as safety, quality, and fairness of the international food trade. These two agencies also developed the International Food Safety Authorities Network (INFOSAN) to rapidly share information during food safety emergencies. Such factors result in the rise in the use of microbial testing for analyses and diagnostics, thereby benefitting the market.
Key Microbial Testing Market Trend
The emergence of new infectious diseases will fuel the global microbial testing market growth. Infectious diseases result in more deaths worldwide than any other single cause. For instance, in 2019,10, million people fell ill due to tuberculosis (TB) worldwide, out of which 5.6 million were men, 3.2 million women, and 1.2 million children. Over 94.82% of tuberculosis-associated deaths occur in low- and middle-income countries. Infectious diseases are caused by pathogenic microorganisms such as viruses, bacteria, parasites, or fungi. Diseases can be transmitted through touch, contaminated food, water, and air. Diseases can also spread through animal and insect bites and sexual contact. With the increase in infectious diseases, there has been an increase in the products used for diagnosing them. Almost all pathogenic organisms can be detected by microbial testing. Researchers aim to have specific microbial testing procedures to detect various pathogens. In recent years, microbial testing for the detection of bacterial infections caused by Escherichia coli (gastroenteritis), Salmonella typhi (food poisoning), and Campylobacter hyointestinalis (gastritis) has increased. Thus, an increase in infectious diseases will increase the demand for its diagnosis with the help of microbial testing, thus increasing the revenue of the market during the forecast period.
Key Microbial Testing Market Challenge
The lack of skilled professionals is a major challenge for the global microbial testing market growth. The use of microbial testing is increasing at a rapid rate. Carrying out efficient testing protocols requires efficient handling of equipment and tests that are compliant with regulatory bodies and GMP. However, with the global increase in disease burden and the increasing pressure on laboratories to produce test results in short TAT, laboratories tend to overlook certain rules and protocols. When low-quality products are identified by regulatory bodies, the company incurs losses, and it practically becomes impossible to relaunch the product or revise testing procedures. In August 2017, in India, the Central Drugs Standard Control Organization declared 37 drugs as unsafe for patient use by identifying them as adulterated, spurious, misbranded, or not of standard quality. Moreover, lack of recognition of the profession and lack of appropriate knowledge about the importance of laboratory professionals are some other reasons contributing to the dwindling number of professionals in laboratories, and this is expected to continue during the forecast period thereby, offsetting the growth of the market.
This microbial testing market analysis report also provides detailed information on other upcoming trends and challenges that will have a far-reaching effect on the market growth. The actionable insights on the trends and challenges will help companies evaluate and develop growth strategies for 2021-2025.
Parent Market Analysis
Technavio categorizes the global microbial testing market as a part of the global life sciences tools and services market. Our research report has extensively covered external factors influencing the parent market growth potential in the coming years, which will determine the levels of growth of the microbial testing market during the forecast period.
Who are the Major Microbial Testing Market Vendors?
The report analyzes the market’s competitive landscape and offers information on several market vendors, including:
- 3M Co.
- Agilent Technologies Inc.
- Bio Rad Laboratories Inc.
- bioMerieux SA
- Danaher Corp.
- F. Hoffmann-La Roche Ltd.
- Merck KGaA
- PerkinElmer Inc.
- Shimadzu Corp.
- Thermo Fisher Scientific Inc.
This statistical study of the microbial testing market encompasses successful business strategies deployed by the key vendors. The microbial testing market is fragmented and the vendors are deploying organic and inorganic growth strategies to compete in the market.
Product Insights and News
- 3M Co. - The company offers microbial testing namely Microbial Luminescence system.
To make the most of the opportunities and recover from post COVID-19 impact, market vendors should focus more on the growth prospects in the fast-growing segments, while maintaining their positions in the slow-growing segments.
The microbial testing market forecast report offers in-depth insights into key vendor profiles. The profiles include information on the production, sustainability, and prospects of the leading companies.
Microbial Testing Market Value Chain Analysis
Our report provides extensive information on the value chain analysis for the microbial testing market, which vendors can leverage to gain a competitive advantage during the forecast period. The end-to-end understanding of the value chain is essential in profit margin optimization and evaluation of business strategies. The data available in our value chain analysis segment can help vendors drive costs and enhance customer services during the forecast period.
The value chain of the global life sciences tools and services market includes the following core components:
- Inputs
- Inbound logistics
- Operations
- Outbound logistics
- Marketing and sales
- Service
- Support activities
- Innovation
The report has further elucidated on other innovative approaches being followed by service providers to ensure a sustainable market presence.
Which are the Key Regions for Microbial Testing Market?
For more insights on the market share of various regions Request for a FREE sample now!
39% of the market’s growth will originate from North America during the forecast period. The US is the key market for the microbial testing market in North America. Market growth in this region will be slower than the growth of the market in regions.
The high prevalence of food-borne diseases will facilitate the microbial testing market growth in North America over the forecast period. This market research report entails detailed information on the competitive intelligence, marketing gaps, and regional opportunities in store for vendors, which will assist in creating efficient business plans.
COVID Impact and Recovery Analysis
The COVID-19 pandemic in 2020 negatively impacted the economy of North America. The pandemic hampered the regional market in focus to a certain extent. The outbreak affected several manufacturing processes and resulted in supply chain disruptions. However, the emergence of the outbreak in 2020 boosted the growth of the regional microbial testing market. The imposition of lockdowns in North America decreased the number of COVID-19 cases in the last quarter of 2020. Furthermore, the widespread vaccination programs are also expected to boost the regional market growth in Q1 2021. Hence, the microbial testing market in North America is expected to grow at a moderate pace during the forecast period.
What are the Revenue-generating Application Segments in the Microbial Testing Market?
To gain further insights on the market contribution of various segments Request for a FREE sample
The microbial testing market share growth by the food and beverages and other segments will be significant during the forecast period. The increase in awareness among consumers for the safety of food products has led to the growing demand for contamination-free products, which has led to advancements in food safety practices in the food industry.
This report provides an accurate prediction of the contribution of all the segments to the growth of the microbial testing market size and actionable market insights on post COVID-19 impact on each segment.
|
Microbial Testing Market Scope |
|
|
Report Coverage |
Details |
|
Page number |
120 |
|
Base year |
2020 |
|
Forecast period |
2021-2025 |
|
Growth momentum & CAGR |
Accelerate at a CAGR of 7.75% |
|
Market growth 2021-2025 |
$ 2.21 billion |
|
Market structure |
Fragmented |
|
YoY growth (%) |
7.30 |
|
Regional analysis |
North America, Europe, Asia, and ROW |
|
Performing market contribution |
North America at 39% |
|
Key consumer countries |
US, Germany, UK, China, and Japan |
|
Competitive landscape |
Leading companies, Competitive strategies, Consumer engagement scope |
|
Key companies profiled |
3M Co., Agilent Technologies Inc., Bio Rad Laboratories Inc., bioMerieux SA, Danaher Corp., F. Hoffmann-La Roche Ltd., Merck KGaA, PerkinElmer Inc., Shimadzu Corp., and Thermo Fisher Scientific Inc. |
|
Market dynamics |
Parent market analysis, Market growth inducers and obstacles, Fast-growing and slow-growing segment analysis, COVID 19 impact and recovery analysis and future consumer dynamics, Market condition analysis for forecast period |
|
Customization purview |
If our report has not included the data that you are looking for, you can reach out to our analysts and get segments customized. |
What are the Key Data Covered in this Microbial Testing Market Report?
- CAGR of the market during the forecast period 2021-2025
- Detailed information on factors that will drive microbial testing market growth during the next five years
- Precise estimation of the microbial testing market size and its contribution to the parent market
- Accurate predictions on upcoming trends and changes in consumer behavior
- The growth of the microbial testing industry across North America, Europe, Asia, and ROW
- A thorough analysis of the market’s competitive landscape and detailed information on vendors
- Comprehensive details of factors that will challenge the growth of microbial testing market vendors
We can help! Our analysts can customize this report to meet your requirements. Get in touch